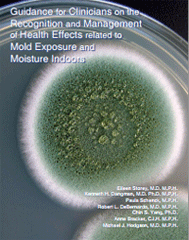

Guidance for Clinicians on the Recognition and Management of Health Effects Related to Mold Exposure and Moisture Indoors
The "Clinician's Guide" was designed to help the healthcare provider address patients with illnesses related to mold in the indoor environment by providing background understanding of how mold may be affecting patients. View the guidance at: